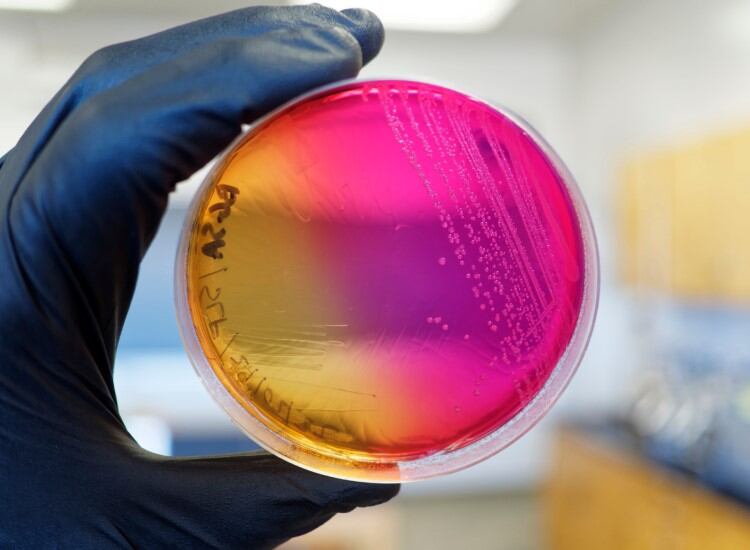

Dutch ingredient supplier celebrates ‘giant leap’ as food industry’s first representative in space
Rotterdam-based Fooditive is boldly going where no food company has gone before to try and solve current food system challenges and drive system transformation.